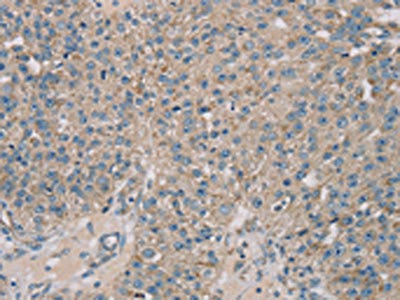

ROBO2 Antibody
-
中文名稱:ROBO2兔多克隆抗體
-
貨號:CSB-PA113101
-
規格:¥1100
-
圖片:
-
其他:
產品詳情
-
Uniprot No.:
-
基因名:
-
別名:lea antibody; Robo 2 antibody; Robo2 antibody; ROBO2_HUMAN antibody; Roundabout 2 antibody; Roundabout homolog 2 antibody; roundabout, axon guidance receptor, homolog 2 (Drosophila) antibody; Roundabout2 antibody; SAX 3 antibody; SAX3 antibody
-
宿主:Rabbit
-
反應種屬:Human
-
免疫原:Synthetic peptide of Human ROBO2
-
免疫原種屬:Homo sapiens (Human)
-
標記方式:Non-conjugated
-
抗體亞型:IgG
-
純化方式:Antigen affinity purification
-
濃度:It differs from different batches. Please contact us to confirm it.
-
保存緩沖液:-20°C, pH7.4 PBS, 0.05% NaN3, 40% Glycerol
-
產品提供形式:Liquid
-
應用范圍:ELISA,IHC
-
推薦稀釋比:
Application Recommended Dilution ELISA 1:1000-1:2000 IHC 1:25-1:100 -
Protocols:
-
儲存條件:Upon receipt, store at -20°C or -80°C. Avoid repeated freeze.
-
貨期:Basically, we can dispatch the products out in 1-3 working days after receiving your orders. Delivery time maybe differs from different purchasing way or location, please kindly consult your local distributors for specific delivery time.
-
用途:For Research Use Only. Not for use in diagnostic or therapeutic procedures.
相關產品
靶點詳情
-
功能:Receptor for SLIT2, and probably SLIT1, which are thought to act as molecular guidance cue in cellular migration, including axonal navigation at the ventral midline of the neural tube and projection of axons to different regions during neuronal development.
-
基因功能參考文獻:
- determined the crystal structure of the tandem Ig4-5 domains (D4-5) of human Robo2 and found that a hydrophobic surface on D4 mediates close homotypic contacts with a reciprocal D4 PMID: 29017837
- ROBO2 variants were not found to be associated with nonsyndromic vesicoureteral reflux with or without renal hypoplasia/dysplasia, providing further evidence for genetic heterogeneity PMID: 27002985
- ROBO2 and RASSF2A gene methylations may be related to gastric tumorigenesis, and ROBO2 gene methylation is associated with sporadic gastric cancer. PMID: 27461616
- Overexpression of ROBO2 induces its tumor suppressive effects in Breast cancer PMID: 26542734
- ROBO2 somatic mutation is associated with myelodysplastic syndrome progression. Overexpression of ROBO2 produces anti-proliferative and pro-apoptotic effects in leukemia cells. This effect was lost in ROBO mutants and ROBO-SLIT2 signaling is impaired. PMID: 26608094
- Common variation near ROBO2 is associated with expressive vocabulary in infancy. PMID: 25226531
- Mutations of the SLIT2-ROBO2 pathway genes SLIT2 and SRGAP1 confer risk for congenital anomalies of the kidney and urinary tract PMID: 26026792
- Down-regulation of ROBO2 expression is associated with prostate cancers. PMID: 24272677
- The finding that a polymorphism associated with the ROBO2 gene, which is involved in neurodevelopment, confers risk for the common emotionally reactive, impulsive aspects of conduct disorder, independent of concurrent risk for psychopathy. PMID: 23982283
- Results not completely rule out that some ROBO2 variants may be the sole cause of vesicoureteric reflux, but it is clear from the overall frequency that most of them cannot be. PMID: 23536131
- two differentially expressed isoforms were isolated and identified. Exons 1 and 2 of human ROBO2a lie in an inherently unstable DNA segment at human chromosome 3p12.3. PMID: 16829019
- Disruption of ROBO2 is associated with urinary tract anomalies and confers risk of vesicoureteral reflux. PMID: 17357069
- a relatively high frequency of ROBO2 variants (5.1%) was found in familial vesicoureteral reflux PMID: 18235093
- mRNA expression of ROBO2 in lymphocytes was significantly reduced in the autistic group PMID: 18270976
- gene variants in ROBO2 are rare causes of VUR in humans. Our results provide further evidence for the genetic heterogeneity of this disorder PMID: 19350278
顯示更多
收起更多
-
相關疾病:Vesicoureteral reflux 2 (VUR2)
-
亞細胞定位:Membrane; Single-pass type I membrane protein.
-
蛋白家族:Immunoglobulin superfamily, ROBO family
-
數據庫鏈接:
Most popular with customers
-
-
YWHAB Recombinant Monoclonal Antibody
Applications: ELISA, WB, IHC, IF, FC
Species Reactivity: Human, Mouse, Rat
-
Phospho-YAP1 (S127) Recombinant Monoclonal Antibody
Applications: ELISA, WB, IHC
Species Reactivity: Human
-
-
-
-
-